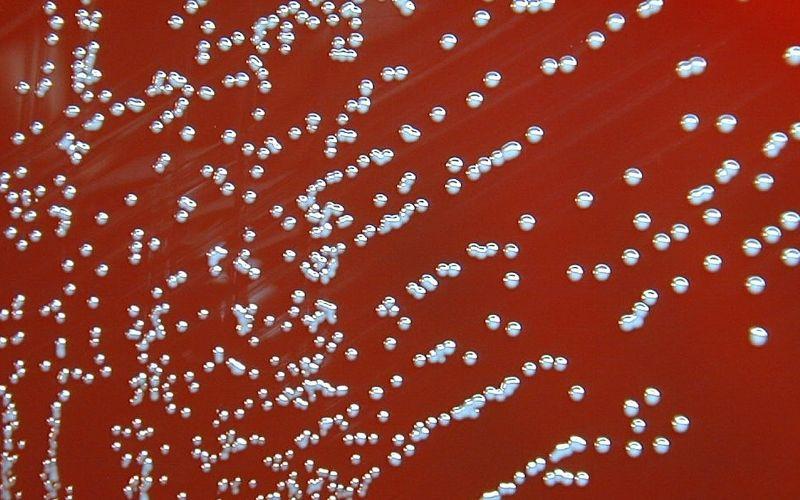

¿Qué es la Brucella melitensis?
Brucella melitensis es una bacteria cocobacilar gramnegativa que produce una enfermedad zoonótica denominada brucelosis ovina y caprina. La infección causa pérdidas económicas importantes al provocar abortos de ovejas y cabras.
A pesar de que esta enfermedad había sido erradicada de algunas naciones, hoy día se considera que B. melitensis es un patógeno reemergente, especialmente en el Medio Oriente.
También es prevalente en el Mediterráneo, Asia Central, África, India, Golfo Arábico y algunos países de América Central y áreas de México.
El humano se puede infectar de forma tangencial con esta bacteria, principalmente las personas expuestas ocupacionalmente, es decir, aquellos que manipulan animales infectados. También se pueden enfermar por el consumo de productos lácteos contaminados.
Características de la Brucella melitensis
– Es un patógeno intracelular facultativo que posee tres biovariedades (1, 2, 3). Todas las biovariedades tienen poder infectante, pero se distribuyen de forma diferente.
– Aunque todas las especies del género Brucella están genéticamente relacionadas, cada especie se asocia con la infección de especies de animales distintos.
– En el caso de Brucella melitensis afecta principalmente a ovejas y cabras. Aunque ocasionalmente se han visto infectando a ganado bovino, camellos, perros e inclusive caballos, cerdos y animales silvestres, pero en menor proporción.
– Es capaz de permanecer viable durante varios meses en diversos sustratos. Entre los más comunes se tienen fetos abortados, estiércol, agua, polvo, suelos, lana, heno, fómites, entre otros.
– Es posible siempre y cuando estén dadas las condiciones de alta humedad, bajas temperaturas, pH cercano a la neutralidad y ausencia de luz solar directa.
– Es sensible a las radiaciones ionizantes (luz ultravioleta por 5 minutos), a la mayoría de los desinfectantes comunes y al calor.
Morfología
– Son cocobacilos o bacilos cortos gramnegativos, de 0,5 a 0,7 µm de diámetro por 0,6-1,5 µm de largo.
– Son no esporulados, no capsulados, no móviles y aerobios facultativos.
– Tienen capacidad para vivir intracelularmente dentro del organismo y multiplicarse en medios de cultivo extracelularmente.
– Se distribuyen de forma aislada, en pares o en grupos.
– Las colonias son pequeñas, convexas, lisas, traslúcidas, levemente amarillentas y opalescentes, y pueden tomar una coloración parda al envejecer.
Factores de virulencia
Las cepas del género Brucella en el laboratorio forman al inicio colonias lisas, y a medida que se van realizando subcultivos sufren variaciones antigénicas y forman colonias rugosas.
Al momento de producir colonias lisas son resistentes a la destrucción intracelular por las células polimorfonucleares, es decir, las lisas son más virulentas que las rugosas.
Por otra parte, presenta dos determinantes antigénicos principales, denominados A y M.
Transmisión
El contacto directo del humano con placentas, fetos, líquidos fetales y fluidos vaginales de animales infectados son la fuente primaria de contagio.
También por ingestión de alimentos (carne, leche, lácteos en general) contaminados o por la inhalación de microorganismos aerosolizados.
Las ovejas siguen eliminando al microorganismo por sus fluidos vaginales durante tres semanas después del parto o aborto. Mientras que las cabras pueden durar 2 a 3 meses liberando la bacteria en los mismos fluidos.
Los animales infectados también excretan de forma prolongada, y en ocasiones permanentemente, el microorganismo a través del calostro, leche y semen. Asimismo, las crías que se amamantan de madres infectadas pueden excretar la bacteria por las heces.
Esto quiere decir que los animales se pueden contagiar tanto por vía horizontal (por el estrecho contacto de unos con otros), como vertical (madre a hijo).
Sirven de puerta de entrada el sistema digestivo, la membrana mucosa orofaríngea, el tracto respiratorio, la conjuntiva y heridas en la piel.
En casos excepcionales por contacto sexual, ya que el contagio por semen se da principalmente en inseminaciones artificiales de los animales.
También el microorganismo se puede diseminar en la naturaleza a través de objetos inanimados, así como por transporte mecánico a través de animales carnívoros, que pueden portar material contaminado cuando cazan cabras u ovejas infectadas.
Patogenia en animales
Una vez que el microorganismo ingresa al organismo por cualquier vía, estos son fagocitados por células del sistema inmunitario. No todas las bacterias sobreviven, pero si no son destruidas se multiplican en el retículo endoplásmico.
Se diseminan por vía hemática, prefiriendo el aparato reproductor del animal y las glándulas mamarias. Se multiplican abundantemente en los cotiledones y el corión placentarios, así como en los líquidos fetales, causando lesiones en la pared del órgano.
Esto provoca una endometriosis ulcerosa en los espacios intercotiledonarios y destrucción de las vellosidades que causan la muerte y expulsión del feto.
Patología y manifestaciones clínicas en animales
La infección con Brucella melitensis en cabras y ovejas no gestantes puede cursar de forma asintomática. En hembras preñadas produce abortos, muertes fetales, partos prematuros y crías débiles.
En los machos puede producir epididimitis, orquitis aguda y prostatitis, que pueden llevar a la infertilidad del animal. También se puede observar, aunque de forma infrecuente, artritis en ambos sexos.
La infección por B. melitensis en otras especies animales no habituales puede provocar los mismos síntomas.
En la necropsia se observan lesiones inflamatorias granulomatosas en el tracto reproductivo, la ubre, ganglios linfáticos supramamarios, articulaciones, membranas sinoviales y otros tejidos linfoides.
Se puede observar placentitis con edema, necrosis de los cotiledones, y un aspecto áspero y engrosado del espacio intercotiledonario.
El feto puede visualizarse de aspecto normal, autolisado o con manchas de sangre y exceso de líquido.
Patogenia en humanos
Los microorganismos entran por la vía digestiva, por piel o mucosas, donde son fagocitados, siendo capaces de sobrevivir dentro de la célula inactivando el sistema de mieloperoxidasa-peróxido.
De allí se transportan a los ganglios linfáticos y se produce una bacteriemia. Posteriormente, hay secuestro de los microorganismos en diversos órganos del sistema reticuloendotelial (hígado, bazo, médula ósea).
Al degenerar el PMN, libera al microorganismo, luego endocitado por otra célula, y este ciclo se vuelve a repetir.
Esto explica los episodios de la fiebre ondulante, asociados al momento de la liberación de las bacterias y de algunos componentes bacterianos, como lipopolisacáridos (LPS).
La liberación de la bacteria a la circulación periférica favorece la siembra hematógena de otros órganos y tejidos. En definitiva, el espectro patológico dependerá de:
– El estado inmune del paciente,
– Presencia de enfermedades subyacentes,
– La especie responsable de la infección, recordando que melitensis es la más virulenta de todas.
Patología y manifestaciones clínicas en el humano
La brucelosis en el humano se conoce con varios nombres, entre ellos: fiebre ondulante, enfermedad de Bang, fiebre de Gibraltar, fiebre del Mediterráneo y fiebre de Malta.
La aparición de los síntomas puede ser insidiosa o abrupta. Los síntomas inespecíficos son:
– fiebre,
– sudoración nocturna,
– escalofríos y malestar general,
– cefalea severa,
– mialgias,
– artralgias.
Estos síntomas pueden estar acompañados de linfadenopatías, esplenomegalia y hepatomegalia. Algunas veces pueden manifestarse lesiones cutáneas similares al eritema nudoso y erupciones maculopapulares o papulonodulares.
La fiebre ondulante debe su nombre a la aparición periódica de la misma. Esta fiebre es generalmente nocturna y cursa durante semanas, meses y años con períodos intercalados sin fiebre, repitiéndose los ciclos. Por tanto se vuelve una enfermedad crónica y debilitante.
Entre las complicaciones más severas que pudieran presentarse se encuentran:
– fatiga crónica,
– endocarditis,
– trombosis de los vasos sanguíneos,
– epidídimo-oruitis,
– nefritis.
A nivel neurológico:
– meningitis,
– hemorragias cerebrales,
– encefalitis,
– uveítis,
– neuritis óptica.
Sobre el sistema respiratorio se puede observar:
– neumonitis intersticial,
– empiema,
– derrame pleural.
En los sistemas gastrointestinal y hepatobiliar:
– colitis,
– enterocolitios o peritonitis espontánea,
– granulomas y microabscesos hepáticos caseosos,
– abscesos esplénicos.
A nivel osteoarticular, artritis (bursitis, sacroilítis, espondilitis y osteomielitis).
Diagnóstico
Las muestras ideales para aislar el microorganismo en el humano son muestras de sangre y médula ósea, también pueden usarse biopsias tisulares y LCR.
El microorganismo crece muy lentamente en frascos de hemocultivos incubados a 35° C durante 4 a 6 semanas, haciendo subcultivos periódicos en agar sangre y chocolate. Los sistemas BACTEC pueden detectar el crecimiento a partir de 7 días de incubación.
Brucella melitensis no produce sulfuro de hidrógeno, no requiere CO₂ para su crecimiento, es catalasa y oxidasa positivo. Crece en presencia de los siguientes colorantes: fucsina básica 20 µg, tionina (20 y 40 µg) y azul tionina 2 µg/mL.
Se pueden hacer extendidos de las colonias aisladas y colorear con Ziehl-Neelsen modificado, usando ácidos débiles. Aunque B. melitensis no es una bacteria propiamente ácido alcohol resistente, bajo esta técnica modificada se teñirá de rojo.
Por último, para el diagnóstico se puede usar la técnica de aglutinación con antisueros específicos.
Tratamiento
Los animales no se tratan, se sacrifican.
En el humano se puede usar una combinación de tetraciclina con un aminoglucósido o también trimetoprim-sulfametoxazol.
Pese al tratamiento y a la remisión de los síntomas, puede haber recidivas.
Referencias
- Koneman, E, Allen, S, Janda, W, Schreckenberger, P, Winn, W. (2004). Diagnóstico Microbiológico.
- Brucelosis Ovina y Caprina: Brucella melitensis (2009). The Center for Food Security & Public Health. Iowa State University.